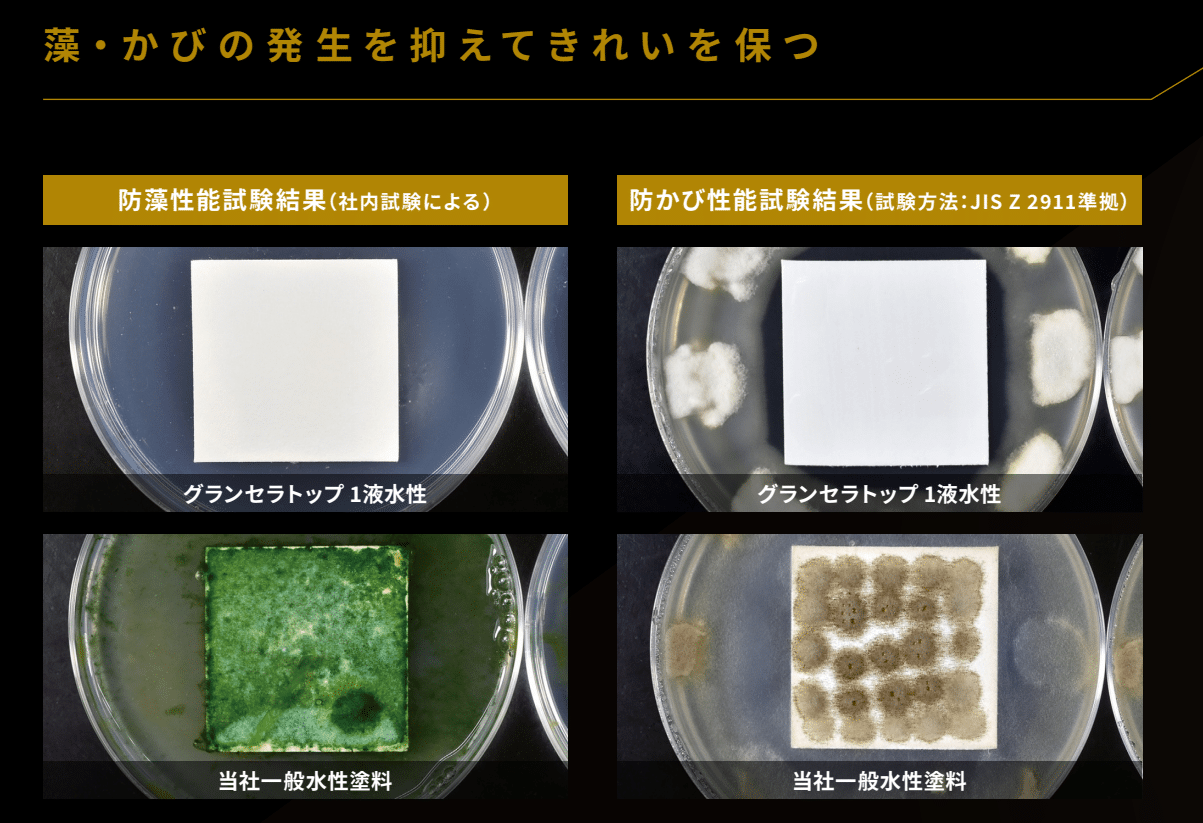
グランセラトップ1液水性の防藻・防かび性能試験結果比較写真。一般水性塗料との差を示す

安心の日本ペイントから究極の無機系塗料!「 グランセラシリーズ 」 のご紹介
📢 2024年10月19日 更新:塗料の名称が変更されました。
旧称「パーフェクトセラミックトップG」→ 新称「グランセラ™️トップ 2液水性」
創業107年以上の塗料問屋が母体の、兵庫県西宮市・芦屋市・宝塚市・川西市・伊丹市で運営する地域密着型塗装店のPaintWall(ペイントウォール)です。
お家の塗り替えリフォームをご検討中のお客様へ向けて、オススメ塗料情報を発信しております。
本日は、日本における塗料のリーディングカンパニーである日本ペイント社から販売されているパーフェクトシリーズより誕生した、究極の無機系高級塗料「グランセラシリーズ」(2024年名称変更:パーフェクトセラミックトップG → グランセラ™️トップ 2液水性)について、塗料の特徴や特性、実際の施工事例まで、まるごとご紹介いたします!
お家の塗り替えをご検討中のお客様必見の塗装お役立ち情報となっております!ぜひ最後までご覧くださいませ。
📋 目次
1. はじめに
2. 日本ペイントについて
4. ハイブリッド無機系塗料 グランセラシリーズ全5商品のラインナップ
7. ペイントウォールだからできるお得に塗り替えできるアピールポイント!
8. よくある質問(FAQ)
🏠 はじめに
住宅の外壁は家の内部を水や風の侵入から守るためにあります。特に日本では、外壁の内部に木が使われることが多く特に水の侵入から守る必要があります。
一方で外壁の塗膜は、常に太陽からの紫外線、赤外線や雨風にさらされることで、新築時から劣化をし続けてしまいます。
そのため、新築から7年以上経ったり前回塗装から一定年数経過すると、外壁表面の塗膜の劣化が進むため住宅の寿命を延ばすためにも「外壁や屋根の塗り替え」工事が必要となります。
外壁塗装は、足場設置が必要で大きな工事になるので費用も100万円以上かかってきます。
そのためせっかく塗り替えるなら、”雨風に強く””汚れが付きにくく””色褪せが少なく”長い期間しっかり家を守れるコストパフォーマンスに優れた塗料を選びたいものです。
つまり塗料としては、紫外線による塗膜の劣化に強い「耐候性」に優れ、雨風等の汚れが付きにくい「耐汚染性」を持ち、色褪せに強く住宅を守ることに関しては他の塗料を凌駕する塗料を選ぶことは大事です。
でもそんな都合の良い塗料ってあるの?あっても高価で手が出ないと感じるかもしれません。
でも実はあるんです!それは、これまでの常識を覆す塗料、「超耐候無機系塗料」です!
無機系塗料は、成分の組み合わせが難しく、塗料としての機能を維持するのが困難な面もあります。しかし、その圧倒的な耐用年数と、汚れに強い耐汚染性のおかげで、塗り替え回数を大幅に減らせます。このため、長期的に見ると非常にコストパフォーマンスに優れた塗料と言えます。
本日は、そんな無機系塗料の中から、日本における塗料のリーディングカンパニーである日本ペイント”ニッペ”が「究極の高耐久塗料」と称した「グランセラシリーズ」をご紹介します。

🎨 日本ペイントについて
日本ペイントは通称 “ニッペ” という愛称で呼ばれる日本における塗料のリーディングカンパニーです。
1898年(明治31年)に日本初の塗料工業会社としてスタートし日本で最も歴史のある塗料会社になります。
おそらく一度は日本ペイントかニッペという言葉を聞いたことがあるのではないでしょうか。
創業当初は海軍への船に塗る塗料(船体塗料)から始まっているので水に強い塗料開発に定評がある会社で、多くの最新塗料を研究開発して販売しており日本での塗料メーカーの売上ランキングはトップとなっています。
💡 日本ペイントはその豊富な資金力で多くの研究開発を行っており、日本ペイントHDの公表情報によると「2022年の研究開発費は281億円に達し、新たに169件の特許を出願。2022年末時点で登録されている特許権は1,508件」に達しています。
年間280億円もの費用を開発にかけているので非常に開発力が高いことが推測できます。
そんな日本ペイントが住宅用にそれまでの研究開発での成果を凝縮して詰め込んだのが究極の高耐久塗料と言われる「グランセラシリーズ」です。
🔬 無機塗料とは? 有機・無機の違い
塗料には、「有機系塗料」と「無機系塗料」があります。
一般的によく知られている塗料のウレタン系、シリコン系、フッ素系は、有機系塗料などと呼ばれています。
【有機系塗料とは?】
一般的に燃える物質には炭素が含まれており、動植物なども有機物にあたります。有機系塗料は、塗料を構成する樹脂や顔料に炭素を含んだ化石燃料(化石燃料は有機物の塊)に由来するもので作られたものです。基本的に有機物質が含まれている塗料です。
そのため太陽光に含まれる紫外線によって劣化しやすい特徴があり、劣化により色あせや、粉状になるチョーキング(白亜化)などの事象が発生します。

▲ 外壁を触ると白い粉が付く「チョーキング(白亜化)」は塗膜劣化のサインです
【無機系塗料とは?】
鉱物(石や砂、金属等)などの炭素が含まれていない物質を無機物と呼びますが、その無機物を樹脂に配合して作られたものを無機系塗料といいます。
無機物の代表であるガラスや石をイメージしていただければわかると思いますが、3,000年前の石板が今でも残っているように無機物は物質的に安定しており紫外線の影響による色褪せを基本的にはせず、風化以外では劣化しないという特性をもっています。
ただ、塗料で「無機」という名称が使われていますが、実際には無機物だけで塗料を作ろうと思うと無機物の特徴である硬さが影響し塗料として最も重要な性能である柔軟性がない塗料になってしまいます。
どんなに耐候性は高くても振動で割れてしまいやすいので現実的ではありません。そのため完全な無機塗料というものは汎用品としてはありません。
そのため実際は無機物の配合量を研究し無機が持つ耐候性を活かしつつ、有機物である樹脂を配合して塗料にしています。
そのため、このグランセラシリーズは、有機と無機の特性を併せ持つ「有機・無機ハイブリッド塗料」として知られています。
無機成分を配合した塗料は以前から存在していましたが、ただ樹脂の中に入れただけではその耐久性の効果は限定的でした。また無機成分が少しでも入っていれば無機塗料と言えてしまうので、無機系塗料だからと言って高耐候性であるとも限りませんでした。
しかしこのグランセラシリーズは無機成分を塗膜の表層に集めるように設計された塗料の為、その無機成分の性能をいかんなく発揮してくれます。
そしてこのグランセラシリーズは無機の耐候性だけでなく、ラジカル制御技術も合わせてダブルの効果で耐候性を高めています。
ラジカルとは、白色顔料の主成分である酸化チタンが紫外線と酸素と光によってラジカルが発生し、そのラジカルが樹脂の結合を壊すことで劣化していきます。
そのラジカルを抑制するために光安定剤を入れ、ラジカルが発生する酸化チタンにバリアー層を設けて発生を抑え封じ込める技術が「ラジカル制御技術」です。
ラジカル制御技術を活用したニッペの「パーフェクトトップ」に無機成分を配合し表層に無機成分が集まるような技術開発をした製品がグランセラシリーズです。

これが日本における塗料のリーディングカンパニーでもある日本ペイントが送り出した「究極の高耐久塗料」と言われる理由です。
ここで、日本ペイントカタログに掲載されている、上塗り塗料のグレードレベル図を見てみましょう。耐候性の面で、無機系塗料がフッ素を超える最上位クラスに位置しています。

🪣 ハイブリッド無機系塗料 グランセラシリーズ全5商品のラインナップ
グランセラシリーズには、外壁用塗料と屋根用塗料を合わせて全5製品のラインナップをご用意しております。詳細をご紹介します。
🏢 外壁塗料(3製品)
外壁用 No.1 グランセラトップ 2液水性
📢 旧名称:パーフェクトセラミックトップG(2024年10月 名称変更) シリーズのフラッグシップモデルです。
特徴:圧倒的な耐候性を誇り、長期間にわたって住まいの美観を維持します。
強み:水性でありながら、従来の常識を覆すほどの強固な塗膜を形成します。
外壁用 No.2 グランセラトップ 1液水性
扱いやすさと高性能を両立した、外壁用の水性1液形無機塗料です。
特徴:2液形のような現場での調合(硬化剤の混合)が不要なため、施工効率に優れています。
強み:1液形でありながら、グランセラの名に恥じない高い耐久性を発揮します。
外壁用 No.3 グランセラトップ 2液ファイン
より過酷な環境や、下地への密着性を重視する場合に適した外壁用塗料です。
特徴:弱溶剤(シンナー)を使用するタイプで、鉄部や付帯部など幅広い素材に塗装可能な2液弱溶剤タイプの塗料です。
強み:既存の下地の種類を選ばず、幅広い塗り替えシーンで活躍します。
🏠 屋根塗料(2製品)
屋根用 No.1 グランセラベスト 2液ファイン
屋根という、住まいの中で最も過酷な環境に耐えるために設計された専用塗料です。
特徴:強い紫外線や雨風にさらされる屋根を、無機の力で徹底的にガードします。
強み:屋根特有の劣化を防ぎ、色あせにくい鮮やかな仕上がりを長く保ちます。
屋根用 No.2 グランセラベスト 2液ファイン遮熱
「高耐候」×「遮熱」。屋根の温度上昇を抑える最新鋭の塗料です。
特徴:グランセラ特有の超高耐候性はそのままに、赤外線を反射する「遮熱性能」をプラス。
強み:屋根の表面温度上昇を抑え、室内環境の快適化とエアコンの負荷軽減に貢献します。
✨ グランセラシリーズの3つの特長
✅ 特徴① 超低汚染性 汚れにくい!
塗装をしても塗料によっては数年で雨筋が発生してきたり、経年による外壁の汚れは気になるところ…
グランセラシリーズは、住宅の外壁に付着した汚れを雨とともに洗い流し美観を維持することが可能です!
その理由として、グランセラシリーズは、「親水性」という機能がとても優れているからです。
「親水性」とは?
水と馴染みやすい性質のことです。親水性の反対が撥水性です。
撥水は水を弾くのですが、親水は水がなじみやすいので水が集まり面となって上から流れていくような性質になります。
撥水は車のガラスで使われることがありますが、車はワイパーや走行中の風の流れで撥水した水滴を吹き飛ばしてくれるので撥水の方が良い場合があります。
一方で、お風呂のガラスや外壁は水滴を飛ばす要素がないので水滴が小さいと自重で落ちていきません。
外壁に付く汚れ(特に黒い汚れ)の成分は、排ガスや塵などが油分と一緒になってついている汚れがほとんどのため、水と油が弾き合うように、親水性の塗料は油分の汚れを弾き、雨などが親水で集まることで重くなり自重で水が面となって汚れを流してくれるので結果汚れにくくなるのです!
これらはセルフクリーニング機能等ともよばれています。

✅ 特徴② 防藻・防かび機能が高い
グランセラシリーズは、藻やかびの発生を抑制し、住宅の美観と清潔な環境を守ります。オプションとして、強力防かびタイプを選択することもできます。
外壁につくコケや藻・かびにお悩みの方も多いのではないでしょうか?
コケや藻は湿度が高かったり北側や近隣に森や木が多く日が当たりにくいところに発生するため、隣家と密接している壁部分や雑草などが多く生えている場所に特に発生しやすくなっています。
また有機系塗料は劣化のスピードが速く塗膜の防水性が切れてくるので塗膜に水分を含みコケや藻・カビが繁殖するスペースができます。
美観を損なうことはもちろん、屋外とはいえかびが発生している環境は人の体にも悪影響を与えます。
グランセラシリーズは、無機成分の耐劣化性が高く表面の防水性が長く生きることや無機成分の安定度で強力な防カビ・防藻材を使えるためカビや藻が付着しづらく、発生しても親水効果や表層の無機の強度等で浸透しにくいのでカビや藻が発生しにくい塗料です。
✅ 特徴③ 美しいつや
グランセラシリーズは高いレベリング性(均一に平らになる力)により、つや感が非常に優れています。
光を平行に反射させる方がつやが良く見えます。逆に凹凸が大きいと光が乱反射するのでつやが少なく見えるのですが、レベリング性に優れているため、光も水もよく通る構造になっていて美観を整えるためにも、また住宅を守り長持ちさせるためにも高い機能を持つ究極の塗料といえます。
【!ご注意!】艶消し仕上げについて
最近は艶感がある塗料よりマットな質感が好まれます。グランセラシリーズ(外壁塗料)も艶消しを行うことができますが、一般的には艶消し材を混入させることで表面に凹凸を出すことで艶を消すのですが、その分表層に元の塗料の成分が減ることや、凹凸が出ることによって塗料の性能が落ちる(カビ・藻の発生や耐候性)ことになります。マットな方が高級感を感じるかもしれませんが
通常で艶がある塗料を艶消しにするとかなり性能が低下することをご理解ください。
ここまで、グランセラシリーズの優れた特長をご紹介いたしましたが、実際に、ペイントウォールでグランセラシリーズを使用して外壁の塗り替えを行った施工事例をご紹介いたします!
📸 グランセラシリーズを使用した 施工写真

下地処理(クラック補修)を行った上で、日本ペイント パーフェクトフィラーで下塗りを行います。ヘアークラック程度であればフィラーで埋まることも。
パーフェクトフィラーは、ひび割れ追従性に優れ、上塗りの吸い込みが少ないため仕上がりを良くします。
そして、グランセラトップ 2液水性(※2024年10月名称変更 旧名称:パーフェクトセラミックトップG)の中塗り専用塗料と上塗りを塗り重ねていきます。
美しいつやのある仕上がりになり、塗りたての美しさを長期間保つことができます!
💪 ペイントウォールだからできるお得に塗り替えできるアピールポイント!
ペイントウォールは、100年以上続く塗料問屋が母体となっておりますので、一般的な塗装業者様と違い塗料の中間マージンがかかっていません。
また、長い歴史から日本ペイントとは特約店契約を結んでおり、強固な協力関係を築いています。
塗料問屋のネットワークを活かして、腕の良い選び抜かれた専属職人をしっかり確保しており、数多くの現場をお任せする代わりに費用を抑えていただいております。
そのため、お客様には外壁塗装をお求めやすい価格で提供することを可能にしております。
POINT 1 カラー追加料金なし!
標準色でも十分色数はありますが、それ以外の色も選択可能で、通常は費用が高い濃い色でも追加料金は不要でお受けしております!
POINT 2 兵庫県西宮市のリフォーム助成金対応!
兵庫県西宮市地域で例年実施されているリフォーム助成金対応施工店でもあります!
POINT 3 充実のアフターフォロー・保証!
長年企業として続いてきた実績を踏まえたアフターフォローや保証によって安心して家をお任せいただける体制を構築しております。
塗料問屋の圧倒的な価格力と品質力をもって、大切なお家を長持ちさせるお得な塗装が実現可能です!
📺 日本ペイントの代表施工店として テレビ取材を受けました!
テレビ大阪「日経スペシャル 関西リーダー列伝」2024年10月27日放送

ペイントウォールと日本ペイントとのパートナーシップは、実は業界内でも広く認められています。
2024年10月27日放送のテレビ大阪「日経スペシャル 関西リーダー列伝」(7チャンネル)にて、日本ペイントに密着した特集が組まれた際、日本ペイントの代表施工店としてペイントウォールが取材協力をいたしました。
実際のグランセラシリーズ施工現場にてペイントウォールの職人がカメラの前でインタビューに応じる場面も放送され、その確かな技術力と施工品質がテレビを通じて広く紹介されました。
系列:テレビ大阪(7チャンネル)/放映時間:毎月最終日曜日 14:00〜15:00、および番組公式YouTubeにて一般公開
このようにペイントウォールは、日本ペイントから信頼を寄せられる施工店として、品質・技術・実績の面で高い評価をいただいております。大切なお家の塗り替えを、ぜひペイントウォールにお任せください。
❓ よくある質問(FAQ)
📍 西宮ショールーム アクセス情報
住所:〒662-0084 兵庫県西宮市樋之池町10-5-101
(関西スーパー苦楽園店様の近くです)
営業時間:10:00〜18:00(土日祝は17:00まで/月曜定休)
フリーダイヤル: 0120-960-244
電話番号:0798-75-0333
FAX番号:0798-75-0334
駐車場:あり(タイムズ苦楽園第3)
お家の塗装に関することは、どんな小さなことでもお気軽にご相談くださいませ!相談&見積りは無料です!
施工エリアは阪神地域(西宮・芦屋・宝塚・川西・伊丹)となっております。神戸エリアにつきましても弊社別部門で対応可能な場合がございますので、お気軽にご相談くださいませ!
✅兵庫県 西宮市・芦屋市・宝塚市・川西市・伊丹市の外壁診断(無料)
✅兵庫県 西宮市・芦屋市・宝塚市・川西市・伊丹市の屋根診断(無料)
✅兵庫県 西宮市・芦屋市・宝塚市・川西市・伊丹市の外壁塗装
✅兵庫県 西宮市・芦屋市・宝塚市・川西市・伊丹市の外壁の補修
✅兵庫県 西宮市・芦屋市・宝塚市・川西市・伊丹市のシーリング補修
✅兵庫県 西宮市・芦屋市・宝塚市・川西市・伊丹市の屋根塗装
✅兵庫県 西宮市・芦屋市・宝塚市・川西市・伊丹市の屋根鉄部塗装
✅兵庫県 西宮市・芦屋市・宝塚市・川西市・伊丹市の屋根カバー工事
✅兵庫県 西宮市・芦屋市・宝塚市・川西市・伊丹市のバルコニーの防水
✅兵庫県 西宮市・芦屋市・宝塚市・川西市・伊丹市のサイディング張替え工事
✅兵庫県 西宮市・芦屋市・宝塚市・川西市・伊丹市の雨漏り対策
✅兵庫県 西宮市・芦屋市・宝塚市・川西市・伊丹市のアパート・マンション外壁塗装
✅兵庫県 西宮市・芦屋市・宝塚市・川西市・伊丹市の収益物件リフォーム
✅兵庫県 西宮市・芦屋市・宝塚市・川西市・伊丹市の打ち放しコンクリート塗装
✅兵庫県 西宮市・芦屋市・宝塚市・川西市・伊丹市のMPCデザインコンクリート施工・モルタル造形
✅兵庫県 西宮市・芦屋市・宝塚市・川西市・伊丹市の内装塗装
✅兵庫県 西宮市・芦屋市・宝塚市・川西市・伊丹市の屋根雨漏り診断(無料)
✅兵庫県 西宮市・芦屋市・宝塚市・川西市・伊丹市の店舗 外内装リフォーム
✅兵庫県 西宮市・芦屋市・宝塚市・川西市・伊丹市のウッドデッキ塗装
✅兵庫県 西宮市・芦屋市・宝塚市・川西市・伊丹市の漆喰塗装

















 初めての
初めての
















